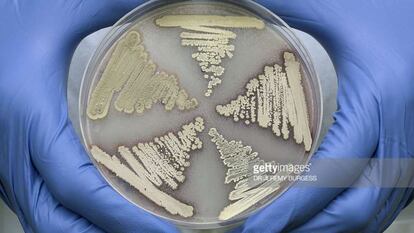

Una mutación global
La resistencia a los antimicrobianos no es sólo un problema de salud, sino también económico. EE UU y Reino Unido han establecido una hoja de ruta para esta crisis
La resistencia a los antimicrobianos no es sólo un problema de salud, sino también económico. EE UU y Reino Unido han establecido una hoja de ruta para esta crisis